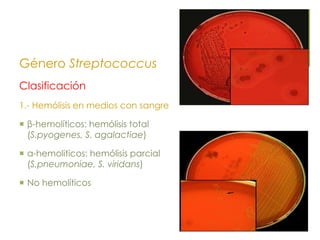
Género Streptococcus
Clasificación
1.- Hemólisis en medios con sangre
 β-hemolíticos: hemólisis total
(S.pyogenes, S. agalactiae)
 α-hemoliticos: hemólisis parcial
(S.pneumoniae, S. viridans)
 No hemolíticos
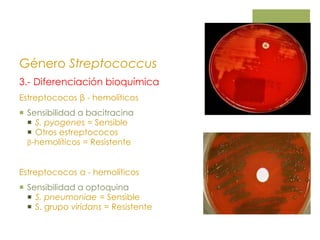
Género Streptococcus
3.- Diferenciación bioquímica
Estreptococos β - hemolíticos
 Sensibilidad a bacitracina
 S. pyogenes = Sensible
 Otros estreptococos
β-hemolíticos = Resistente
Estreptococos α - hemolíticos
 Sensibilidad a optoquina
 S. pneumoniae = Sensible
 S. grupo viridans = Resistente

Este documento describe los géneros bacterianos Streptococcus y Enterococcus. Explica las características generales, clasificación, patogenicidad y cuadros clínicos asociados a las especies más comunes como S. pyogenes, S. pneumoniae, S. agalactiae y Enterococcus faecalis.